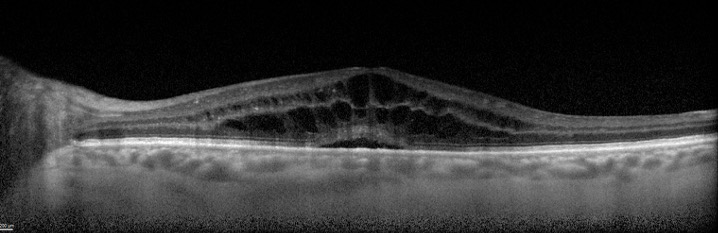

Cystoid Macular Edema
Cystoid Macular Edema
Cystoid macular edema (CME) is a condition that involves the accumulation of fluid within the layers of the macula, the central part of the retina that provides fine, detailed vision. CME can reduce central vision and impacts critical fine visual tasks such as reading.
Symptoms
Cystoid macular edema symptoms can include:
- Blurry central vision
- Altered color saturation
- Straight lines may appear bent
Peripheral vision is usually not affected by this condition. Some patients may be asymptomatic.